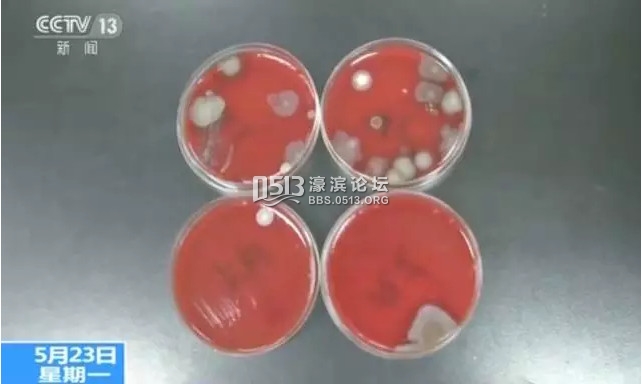
2.jpg

- 阅读权限
- 40
- 精华
- 最后登录
- 1970-1-1
- 在线时间
- 小时
- 主题
- 好友
- 相册
- 分享
- 日志
- 记录
- UID
- 1029788
- 帖子
- 0
该用户从未签到
|
天气越来越热,又到了开空调的季节,一般在使用前,我们都会把它好好地清洁一下,比如,将滤网拆卸下来进行清洗,擦拭落在机体上的灰尘等。但是,这样的清洁方法真的能把空调洗干净吗?% q; V/ L* ^- f2 h
9 t: v! I% |$ ?1 l
室内空调这三个地方最脏
7 M8 |; K! C Q/ C- i
: K: k0 V4 x6 G* O# b# l. Z0 X专业的家电清洁人员表示,不管是挂式、柜式空调,有三个地方最脏,分别是/ z- z; b5 N3 ]
0 w- C- E4 R& h: B+ r7 J% @ 滤网:体积较大的灰尘、污渍等颗粒物会附着在滤网上。2 M0 E+ F8 Z6 K8 D
; e7 H) g; n: ^* Z% {: W7 o" V 蒸发器:空调蒸发器即我们常说的冷热交换器,蒸发器的作用是带走室内的热气,同时将冷气传送到室内。由于冷热空气作用产生的水汽长期封闭在阴暗环境中,再粘上灰尘,就很容易滋生细菌,这时如果打开空调,细菌就会随着空气吹入房间。! G `$ E* e: ~# N7 L$ C% U" b1 G
' z7 O1 L8 l0 U% ?! K
风轮:灰尘长期沉积在此,应重点对这里进行清洁。
# U, e" Y- d- t' n% f7 z. h4 h2 H: q# g7 V% e
空调有多脏?实验看真切
& F5 f" u7 G9 a% J0 F* C
! K# |0 x9 _- s& y那么,空调这些最脏的部位都粘附着什么细菌?会含有致病菌吗?为了验证,记者使用无菌棉拭子,分别提取了一台柜式空调和一台挂式空调蒸发器和风轮表面的物质,并将两个提取的样本送往了西安交大医学部免疫学与病原生物学实验室。4 i$ Q( L# m& ~. G
0 e9 l E# |- d0 _+ h

0 C6 D9 y& c7 {! \
, e3 q3 X; x* j% x经过48小时的培养,实验员从保温箱中取出平板培养皿,之前涂抹在平板表面的样本已经滋生出了大大小小灰黑色的菌落,不仅有多种细菌,还有霉菌。, O& k# j9 m7 l0 W0 L
" M: n. O$ d3 L7 t' N
( ~" c$ U J$ ?' s# z
( ~" c$ U J$ ?' s# z
' |) q5 R( h+ V! c- d专家说,一般的环境微生物对于身体健康的人不会有太大影响,但是对于身体比较弱的人群来说,就有可能会引发疾病。对于方便拆卸的空调滤网,消费者可以每一到两个星期清洗一次。而对于一些身体较弱的或易过敏人群,每年使用空调前最好还是请专业人士来进行内部清洗,避免微生物随着空调的风吹入房间。
' ? V% n7 R2 ^% {& m# K7 Z( }2 F# T' [: Z3 H& z2 c; G
四步教你正确清洁空调; J+ C* h$ m/ e( y6 w* b( c
+ _$ m+ x; s# u5 h* }& e6 {室内空调清洁大致可分四步,重点需要清洗的部位包括室内机外壳、过滤网、散热器、冷凝器、空调出风口及滚轮。& W" E; y) R) z, c/ y6 f# t1 |
9 E- b. _8 ~; c6 P! @
第一步:外壳和滤网的清洗* B3 k" @, W A3 V+ w, @; w$ N' }0 z
- h. ? F& P$ j
空调外壳上积累的灰尘是最显而易见的,也是最容易清理的。在清理空调的灰尘时,我们应该首先将空调的外壳打开,然后将空调内的滤网拆卸下来。! c) \0 Z) Q+ ?
9 M: Q* H: E- g8 B9 B
 * d" y1 U) b6 v+ G1 B& A. z* R
* d" y1 U) b6 v+ G1 B& A. z* R
( L6 B2 g3 p) B- b3 K, q# i# o2 S空气中大部分的灰尘都会累积在滤网之上。空调的滤网质地比较脆弱,因此清洗时需要格外注意不要弄破,再将滤网放置在温水中浸泡,最后清洗干净晾干,再将滤网安装回空调中即可。由于滤网易断裂,因此不能用洗衣粉、清洁剂等强力清洁用品进行清洗。
9 H' I4 \3 Y! a% v% H4 D" K
6 e! @& n" {6 z) h7 ?' r# E
 ( M4 V% o6 n( `5 V2 k9 I4 {
( M4 V% o6 n( `5 V2 k9 I4 {
% q# i& E! C, T0 A. s% Q
第二步:蒸发器的清洗2 U K: @9 U4 K! ^1 G( L! q! I6 b5 I
6 d+ x7 g. q3 k- Z* g5 D5 j. K
对蒸发器进行清洁的过程也很简单,只需要购买专业的蒸发器清洗剂,摇匀后喷在蒸发器的进风一侧,然后再用抹布轻轻擦拭即可。要注意,一定要等蒸发器晾干后,才可再次开启空调。0 a) ~; `: l; g6 t% v7 Q
4 K1 C% h3 H& o+ V
 # k2 {4 ]9 j* S; i8 v
# k2 {4 ]9 j* S; i8 v
( e9 \1 {8 d* L! X* U5 z. z
第三步:冷凝器的清洗2 B5 N9 `! T7 o& T: y& A R& n
! ^( k; O% D3 h) C7 r空调冷凝器安装在压缩机的排气口附近,冷凝器顾名思义是用于制造冷风的机器。冷凝器的清洗最好选择专业的冷凝器清洗剂,否则容易破坏冷凝器的工作效率。在家居保养和清洗时,只需要将冷凝器清洗剂喷洒在冷凝器上即可,或者用清水冲洗也可。& R0 Q! z. x4 T" s' x
% C1 I# _7 k, U7 K6 p7 m
第四步:出风口及滚轮的清洗
$ o( B' Y6 b; T) d' {0 e, Y! s6 n" ]. X! z& [, u
在客厅空调进出口一般积累着厚厚的灰尘,而滚轮上的一些凹槽和间隙位置也很容易积累灰尘,这些灰尘如果不及时清理,将会堵塞空调的出风口,影响出口的出风质量。用细毛刷子耐心地将灰尘刷出,确保出风口和滚轮不受损。" S# o6 s6 S" [ b& B/ {- H
6 G& n. g0 A _- j! `9 B
 4 `; _/ y4 B3 B# ~
4 `; _/ y4 B3 B# ~
" \9 V7 m3 @/ D. S$ d7 n6 z
南通0 |
|
 苏公网安备 32060202000307号 © 2001-2019 0513.org All Right Reserved.
苏公网安备 32060202000307号 © 2001-2019 0513.org All Right Reserved.